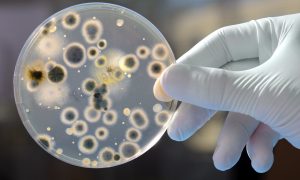
Ученые изобрели антибиотик, который обманывает бактерии

Технологии
-
Новости Технологии30 Октября 09:34
В Шанхае появится фабрика, где роботы будут делать сами себя

-
Новости Технологии30 Октября 09:23
Деятельность человека привела к резкому сокращению числа животных и мощному экокризису

-
Новости Технологии30 Октября 08:22
Австрия введет для электрокаров отдельные полосы и разрешит ездить быстрее

-
Новости Технологии29 Октября 17:17
В Нидерландах создали первый напечатанный мост

-
Новости Технологии29 Октября 11:15
В Google может появиться новая платная подписка

-
Новости Технологии29 Октября 10:45
IBM купит компанию Red Hat

-
Видео Технологии29 Октября 08:23
Видео: NASA показало испытания парашюта для Марса

-
Видео Технологии28 Октября 17:48
Видео: США показали новое противоракетное оружие в действии

-
Новости Технологии28 Октября 15:30
Ученые изобрели антибиотик, который обманывает бактерии
-
Фото Технологии28 Октября 13:05
Ученые разработали робота из жидкого металла, как в «Терминаторе»


